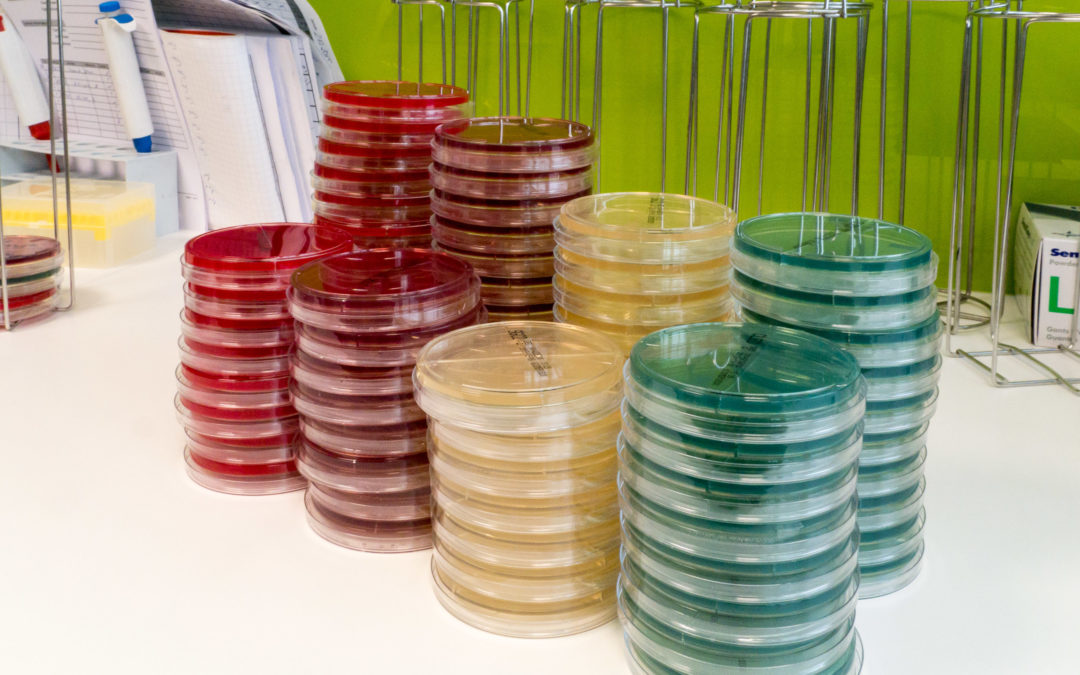
Vorsorge nicht aussetzen

von adminURO21 | Mai 6, 2021 | Uncategorized
Das neuartige Corona-Virus hat den Alltag verändert. Auch bei uns. Das bedeutet jedoch nicht, dass Sie auf unsere Betreuung, Beratung oder Behandlung verzichten müssen. Dennoch gibt es einige Veränderungen, die auch unseren Praxis-Alltag betreffen. Damit Sie so...

von adminURO21 | Mai 6, 2021 | Uncategorized
Unser Labor ist das Rückgrat unserer täglichen Arbeit. Schnelle und zuverlässige Befunde, die Möglichkeit, bei Unklarheiten ein Probe erneut zu analysieren. Selbstverständlich für uns. Mit unserem Blick hinter die Kulissen, zeigen wir Ihnen, wir unser Labor arbeitet...

von adminURO21 | Mai 6, 2021 | Uncategorized
Unser Labor ist das Rückgrat unserer täglichen Arbeit. Schnelle und zuverlässige Befunde, die Möglichkeit, bei Unklarheiten ein Probe erneut zu analysieren. Selbstverständlich für uns. Mit unserem Blick hinter die Kulissen, zeigen wir Ihnen, wir unser Labor arbeitet...

von adminURO21 | Mai 6, 2021 | Uncategorized
Selbstverständlich sollten wir Kontakte meiden, wo immer möglich. Das gilt jedoch nicht für medizinische Vorsorge. Denn mit den gebotenen Vorsichtsmaßnahmen und Vorkehrungen ist Vorsorge auch während der Pandemie möglich. Um Ihren Besuch in unserer Praxis so sicher...

von adminURO21 | Mai 6, 2021 | Uncategorized
Das neuartige Corona-Virus hat den Alltag verändert. Auch bei uns. Das bedeutet jedoch nicht, dass Sie auf unsere Betreuung, Beratung oder Behandlung verzichten müssen. Dennoch gibt es einige Veränderungen, die auch unseren Praxis-Alltag betreffen. Damit Sie so...